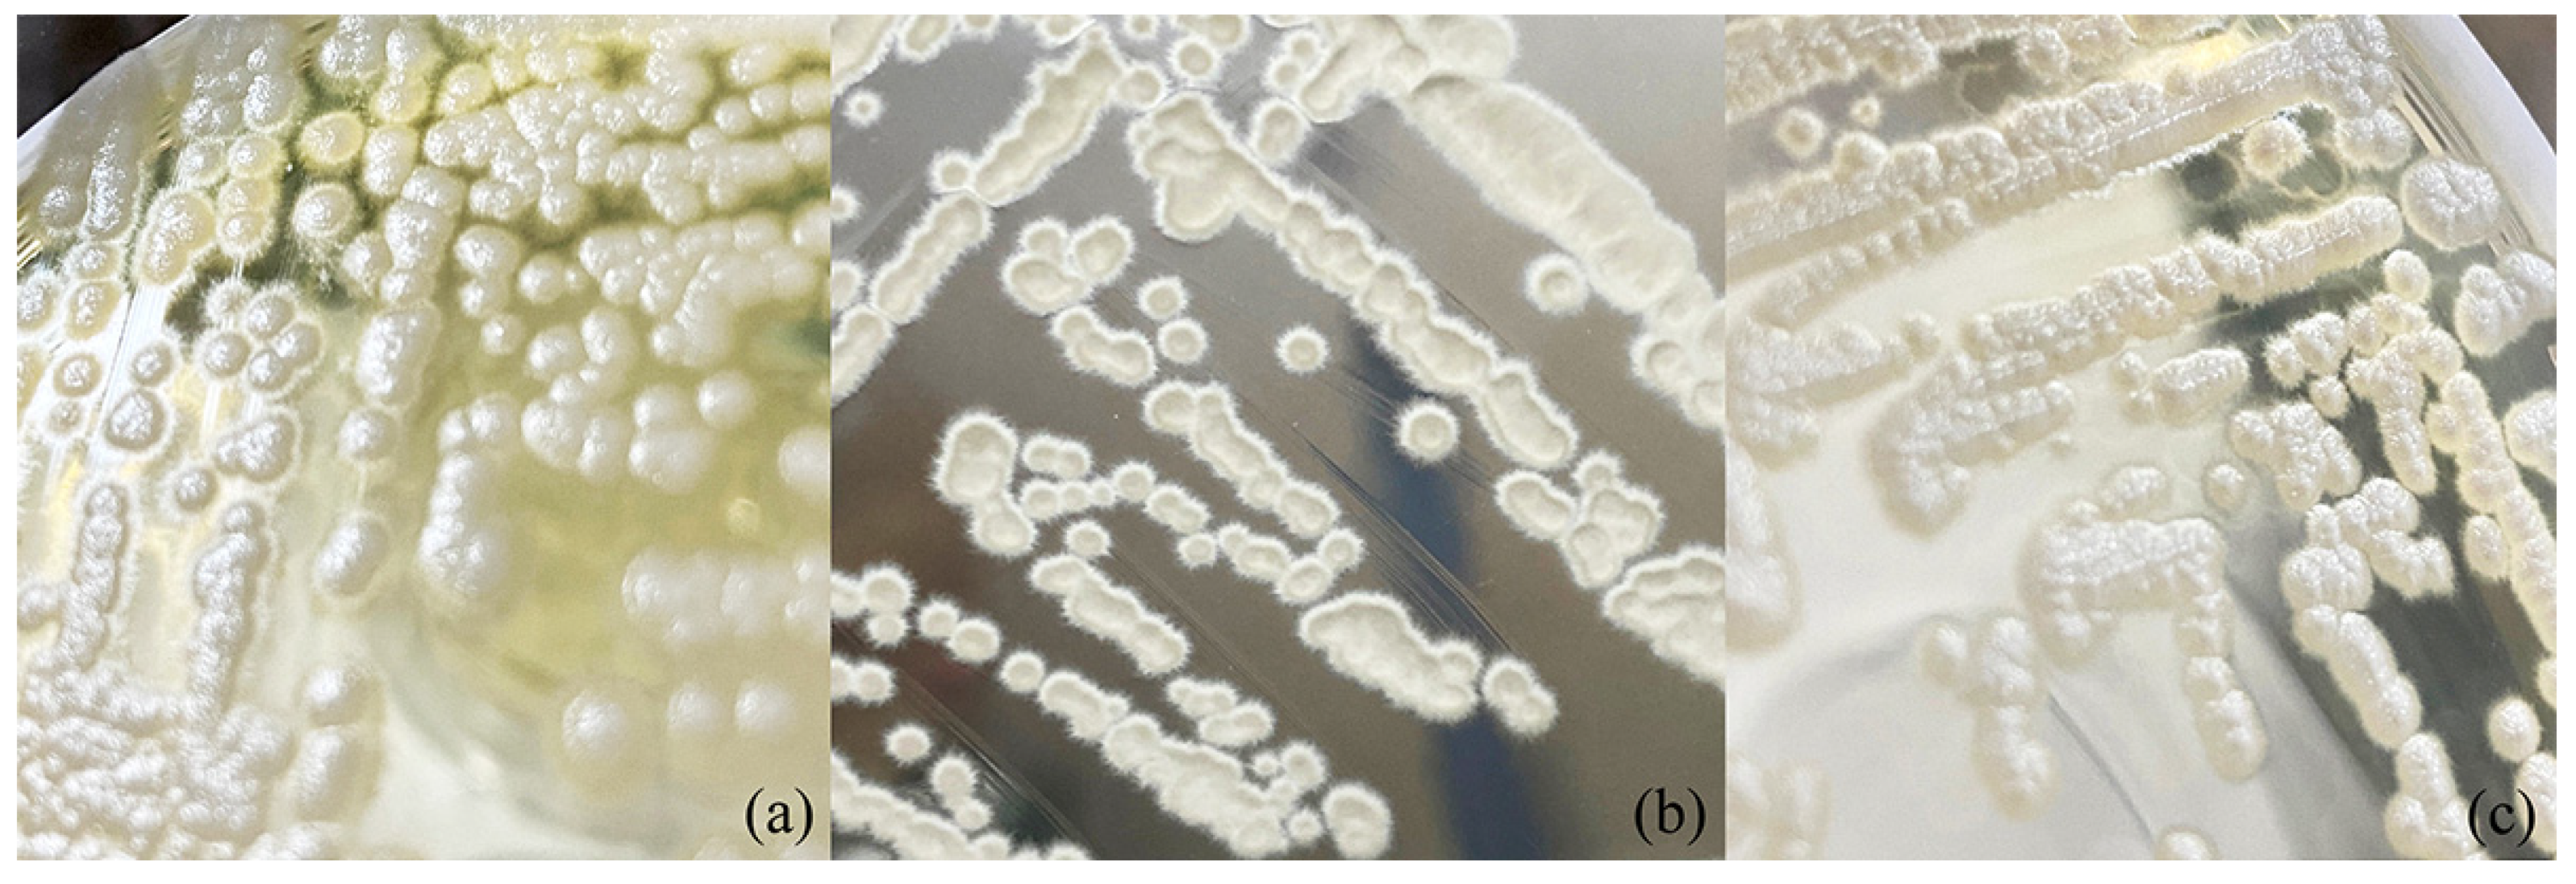
Jof 08 00224 g003 550

Description of Crinitomyces reliqui gen. nov., sp. nov. and Reassignment of Trichosporiella flavificans and Candida ghanaensis to the Genus Crinitomyces
Abstract
:1. Introduction
2. Materials and Methods
2.1. Yeast Isolation
2.2. DNA Sequencing and Phylogenetic Analysis
2.3. Phenotypic Characterization
3. Results
3.1. Species Delineation and Molecular Phylogeny
3.2. Ecology
3.3. Taxonomy
4. Conclusions and Discussion
Supplementary Materials
Author Contributions
Funding
Institutional Review Board Statement
Informed Consent Statement
Data Availability Statement
Acknowledgments
Conflicts of Interest
References
- Boekhout, T.; Aime, M.C.; Begerow, D.; Gabaldon, T.; Heitman, J.; Kemler, M.; Khayhan, K.; Lachance, M.A.; Louis, E.J.; Sun, S.; et al. The evolving species concepts used for yeasts: From phenotypes and genomes to speciation networks. Fungal Divers. 2021, 109, 27–55. [Google Scholar] [CrossRef] [PubMed]
- Lucking, R.; Aime, M.C.; Robbertse, B.; Miller, A.N.; Ariyawansa, H.A.; Aoki, T.; Cardinali, G.; Crous, P.W.; Druzhinina, I.S.; Geiser, D.M.; et al. Unambiguous identification of fungi: Where do we stand and how accurate and precise is fungal DNA barcoding? IMA Fungus 2020, 11, 14. [Google Scholar] [CrossRef] [PubMed]
- Moncada, B.; Lücking, R.; Suárez, A. Molecular phylogeny of the genus Sticta (lichenized Ascomycota: Lobariaceae) in Colombia. Fungal Divers. 2014, 64, 205–231. [Google Scholar] [CrossRef]
- Lücking, R.; Forno, M.D.; Moncada, B.; Coca, L.F.; Vargas-Mendoza, L.Y.; Aptroot, A.; Arias, L.J.; Besal, B.; Bungartz, F.; Cabrera-Amaya, D.M.; et al. Turbo-taxonomy to assemble a megadiverse lichen genus: Seventy new species of Cora (Basidiomycota: Agaricales: Hygrophoraceae), honouring David Leslie Hawksworth’s seventieth birthday. Fungal Divers. 2017, 84, 139–207. [Google Scholar] [CrossRef]
- Merényi, Z.; Varga, T.; Hubai, A.G.; Pitlik, P.; Erős, Á.; Trappe, J.M.; Bratek, Z. Challenges in the delimitation of morphologically similar species: A case study of Tuber brumale agg. (Ascomycota, Pezizales). Mycol. Prog. 2017, 16, 613–624. [Google Scholar] [CrossRef]
- Daniel, H.M.; Lachance, M.A.; Kurtzman, C.P. On the reclassification of species assigned to Candida and other anamorphic ascomycetous yeast genera based on phylogenetic circumscription. Antonie Van Leeuwenhoek 2014, 106, 67–84. [Google Scholar] [CrossRef]
- Kurtzman, C.P.; Robnett, C.J.; Blackwell, M. Description of Teunomyces gen. nov. for the Candida kruisii clade, Suhomyces gen. nov. for the Candida tanzawaensis clade and Suhomyces kilbournensis sp. nov. FEMS Yeast Res. 2016, 16, fow041. [Google Scholar] [CrossRef] [Green Version]
- Lachance, M.; Boekhout, T.; Scorzetti, G.; Fell, J.W.; Kurtzman, C.P. Candida Berkhout The Yeasts, a Taxonomic Study; Elsevier: Amsterdam, The Netherlands, 1923; pp. 987–1278. [Google Scholar]
- Urbina, H.; Blackwell, M. Multilocus Phylogenetic Study of the Scheffersomyces Yeast Clade and Characterization of the N-Terminal Region of Xylose Reductase Gene. PLoS ONE 2012, 7, e39128. [Google Scholar] [CrossRef] [Green Version]
- Kurtzman, C.P.; Robnett, C.J. Three new anascosporic genera of the Saccharomycotina: Danielozyma gen. nov., Deakozyma gen. nov. and Middelhovenomyces gen. nov. Antonie Van Leeuwenhoek 2014, 105, 933–942. [Google Scholar] [CrossRef]
- Khunnamwong, P.; Lertwattanasakul, N.; Jindamorakot, S.; Limtong, S.; Lachance, M.A. Description of Diutina gen. nov., Diutina siamensis, f.a. sp. nov., and reassignment of Candida catenulata, Candida mesorugosa, Candida neorugosa, Candida pseudorugosa, Candida ranongensis, Candida rugosa and Candida scorzettiae to the genus Diutina. Int. J. Syst. Evol. Microbiol. 2015, 65, 4701–4709. [Google Scholar] [CrossRef]
- Kurtzman, C.P. Description of Martiniozyma gen. nov. and transfer of seven Candida species to Saturnispora as new combinations. Antonie Van Leeuwenhoek 2015, 108, 803–809. [Google Scholar] [CrossRef] [PubMed]
- Kurtzman, C.P. Description of Groenewaldozyma gen. nov. for placement of Candida auringiensis, Candida salmanticensis and Candida tartarivorans. Antonie Van Leeuwenhoek 2016, 109, 1041–1045. [Google Scholar] [CrossRef] [PubMed]
- Boontham, W.; Angchuan, J.; Boonmak, C.; Srisuk, N. Limtongozyma siamensis gen. nov., sp. nov., a yeast species in the Saccharomycetales and reassignment of Candida cylindracea to the genus Limtongozyma. Int. J. Syst. Evol. Microbiol. 2020, 70, 199–203. [Google Scholar] [CrossRef] [PubMed]
- Sakpuntoon, V.; Angchuan, J.; Boontham, W.; Khunnamwong, P.; Boonmak, C.; Srisuk, N. Grease Waste as a Reservoir of Lipase-Producing Yeast and Description of Limtongella siamensis gen. nov., sp. nov. Microorganisms 2019, 8, 27. [Google Scholar] [CrossRef] [Green Version]
- Miles, D.J.; Busser, K.; Stalder, C.; Higgins, D.R. Isolation of Nucleic Acids. In Pichia Protocols; Higgins, D.R., Cregg, J.M., Eds.; Humana Press: Totowa, NJ, USA, 1998; Volume 103, pp. 73–80. [Google Scholar]
- Rosa, C.A.; Lachance, M.A.; Teixeira, L.C.; Pimenta, R.S.; Morais, P.B. Metschnikowia cerradonensis sp. nov., a yeast species isolated from ephemeral flowers and their nitidulid beetles in Brazil. Int. J. Syst. Evol. Microbiol. 2007, 57, 161–165. [Google Scholar] [CrossRef] [Green Version]
- Kurtzman, C.; Robnett, C. Phylogenetic relationships among yeasts of the complex determined from multigene sequence analyses. FEMS Yeast Res. 2003, 3, 417–432. [Google Scholar] [CrossRef] [Green Version]
- Kurtzman, C.P.; Robnett, C.J. Identification and phylogeny of ascomycetous yeasts from analysis of nuclear large subunit (26S) ribosomal DNA partial sequences. Antonie Van Leeuwenhoek 1998, 73, 331–371. [Google Scholar] [CrossRef]
- Hall, T.A. BioEdit: A user-friendly biological sequence alignment editor and analysis program for Windows 95/98/NT. Nucl. Acids Symp. Ser. 1999, 41, 95–98. [Google Scholar]
- Kumar, S.; Stecher, G.; Tamura, K. MEGA7: Molecular Evolutionary Genetics Analysis version 7.0 for bigger datasets. Mol. Biol. Evol. 2016, 33, 1870–1874. [Google Scholar] [CrossRef] [Green Version]
- Felsenstein, J. Confidence limits on phylogenies: An approach using the bootstrap. Evolution 1985, 39, 783–791. [Google Scholar] [CrossRef]
- Kurtzman, C.P.; Fell, J.W.; Boekhout, T.; Robert, V. Methods for Isolation, Phenotypic Characterization and Maintenance of Yeasts. In The Yeasts, a Taxonomic Study, 5th ed.; Kurtzman, C.P., Fell, J.W., Boekhout, T., Eds.; Elsevier: Amsterdam, The Netherlands, 2011; pp. 87–110. [Google Scholar]
- Fowell, R.R. Sodium acetate agar as a sporulation medium for yeasts. Nature 1952, 170, 578. [Google Scholar] [CrossRef] [PubMed]
- Kurtzman, C.P.; Fell, J.W.; Boekhout, T. The Yeasts, a Taxonomic Study, 5th ed.; Elsevier: Amsterdam, The Netherlands, 2011; Volume 1. [Google Scholar]
- Kurtzman, C.P. Four new Candida species from geographically diverse locations. Antonie Van Leeuwenhoek 2001, 79, 353–361. [Google Scholar] [CrossRef] [PubMed]
- Nakase, T. Three new asporogenous yeasts found in industrial waste water. Antonie Van Leeuwenhoek 1975, 41, 201–210. [Google Scholar] [CrossRef] [PubMed]
- de Hoog, G.S.; Rantio-Lehtimaki, A.H.; Smith, M.T. Blastobotrys, Sporothrix and Trichosporiella: Generic delimitation, new species, and a Stephanoascus teleomorph. Antonie Van Leeuwenhoek 1985, 51, 79–109. [Google Scholar] [CrossRef] [PubMed]

| Yeast | Source of Isolation | Geographical Origin |
|---|---|---|
| Crinitomycesreliqui sp. nov. | ||
| DMKU-FW23-23T | Domestic food waste trap | Thailand |
| CBS 15014 | Soil taken from 2 cm deep in Utrecht | The Netherlands |
| CBS 161.94 | Sewage sludge in Katowice | Republic of Poland |
| CBS 142641 | Sediment from wastewater treatment facility in Zeewolde | The Netherlands |
| CBS 15,240 (=NCAIM Y.01958) | Water of Danube Budapest (Location 1, 47.484163; 19.054271) | Hungary |
| CBS 15,241 (=NCAIM Y.02184) | Water of Danube Budapest (Location 2, 47.594721; 19.070331) | Hungary |
| CBS 15242 | Water of Danube Budapest (Location 2, 47.594721; 19.070331) | Hungary |
| CBS 15,243 (=NCAIM Y.02185) | Water of Danube Budapest (Location 3, 47.592204; 19.069164) | Hungary |
| Trichosporiella flavificans | ||
| CBS 760.79T | Washings of ion-exchange resin in a guanosine monophosphate manufacturing plant | Japan |
| DMKU-GTSC2-8 | Food waste trap of Faculty of Science, KU canteen | Thailand |
| DMKU-GTSC2-2 | Food waste trap of Faculty of Science, KU canteen | Thailand |
| DMKU-GTCC5-6 | Food waste trap of KU central canteen | Thailand |
| DMKU-GTCC5-12 | Food waste trap of KU central canteen | Thailand |
| DMKU-GTCC5-19 | Food waste trap of KU central canteen | Thailand |
| CBS 15,244 (=NCAIM Y.02186) | Water of Danube Budapest (Location 3, 47.592204; 19.069164) | Hungary |
| CBS 15245 | Water of Danube Budapest (Location 3, 47.592204; 19.069164) | Hungary |
| Candida ghanaensis | ||
| CBS 8798T | Soil in Ghana | Ghana |
| Yeasts | Strain | SSU | ITS | D1/D2 |
|---|---|---|---|---|
| Botryozyma nematodophila | CBS 7426T | NG061133 | NR111167 | NG042439 |
| Candida caryicola | CBS 8847T | - | NR077194 | NG055176 |
| Candida galis | CBS 8842T | - | NR151797 | NG058980 |
| Candida ghanaensis | CBS 8798T | NG065532 | KY102101 | NG055180 |
| Candida haemulonii | CBS 5149T | NG063413 | NR130669 | JX459759 |
| Candida maltosa | CBS 5611T | - | NR138346 | KY106554 |
| Candida tropicalis | CBS 94T | EU348785 | NR111250 | NG054834 |
| Clavispora lusitaniae | CBS 6936T | NG065595 | NR130677 | NG055408 |
| Crinitomycesreliqui | DMKU-FW23-23T | OK275053 | MW720560 | OK298472 |
| Crinitomycesreliqui | CBS 15014 | OK275054 | GU195664 | OK298471 |
| Crinitomycesreliqui | CBS 161.94 | OK275055 | MG250346 | OK298463 |
| Crinitomycesreliqui | CBS 142641 | OK275056 | MG250347 | OK298464 |
| Crinitomycesreliqui | CBS 15,240 (NCAIM Y.01958) | OK275057 | MZ331539 | OK298466 |
| Crinitomycesreliqui | CBS 15,241 (NCAIM Y.02184) | OK275058 | MZ312239 | OK298468 |
| Crinitomycesreliqui | CBS 15242 | OK275059 | MZ312240 | OK298469 |
| Crinitomycesreliqui | CBS 15,243 (NCAIM Y.02185) | OK275060 | MZ312241 | OK298470 |
| Davidhawksworthia ilicicola | CBS 734.94T | - | NR154008 | NG067307 |
| Deakozyma indianensis | NRRL YB-1937T | NG061171 | KJ476205 | NG064315 |
| Debaryomyces hansenii | NRRL Y-7426T | NG063420 | NR120016 | NG042634 |
| Dermea chinensis | CFCC 53008T | - | NR171069 | NG073667 |
| Diddensiella santjacobensis | CBS 8183T | NG063433 | NR151808 | NG058985 |
| Dipodascus albidus | CBS 766.85T | MK834548 | AY788342 | NG066154 |
| Dipodascus carabidarus | CBS 9891T | - | NR155144 | NG058292 |
| Dipodascus cucujoidarus | NRRL Y-27731T | - | NR111352 | NG055370 |
| Dipodascus geniculatus | CBS 184.80T | NG064797 | AY788301 | NG066466 |
| Dipodascus histeridarus | CBS 9892T | - | NR111351 | NG042466 |
| Dipodascus tetrasporeus | CBS 10071T | AB300502 | AB300502 | AB300502 |
| Diutina catenulata | CBS 565T | - | NR077200 | NG059158 |
| Diutina siamensis | DMKU-RE43T | - | KT336715 | KT336715 |
| Geotrichum candidum | CBS 772.71T | JQ698930 | HE663404 | JQ689071 |
| Hanseniaspora valbyensis | CBS 479T | NG063247 | NR111113 | NG042630 |
| Kluyveromyces marxianus | CBS 712T | - | NR111251 | NG042627 |
| Kockiozyma suomiensis | CBS 7251T | NG062713 | NR155335 | NG055355 |
| Kregervanrija fluxuum | CBS 2287T | NG063291 | NR111196 | NG042445 |
| Lachancea thermotolerans | NRRL Y-8284T | NG061071 | NR111334 | NG042626 |
| Limtongia smithiae | CBS 7407T | NG062712 | NR138235 | NG055354 |
| Lipomyces anomalus | CBS 6740T | NG062697 | KT923624 | NG055345 |
| Lipomyces starkeyi | CBS 1807T | - | NG055350 | NR077109 |
| Magnusiomyces magnusii | NRRL Y-17563T | MK834553 | AY788307 | MK834532 |
| Metschnikowia bicuspidata | CBS 5575T | NG065596 | KY104192 | KY108455 |
| Meyerozyma guilliermondii | CBS 2030T | NG063363 | NR111247 | NG042640 |
| Middelhovenomyces petrohuensis | CBS 8173T | NG063431 | NR156314 | NG055211 |
| Middelhovenomyces tepae | CBS 5115T | NG063435 | NR154200 | NG055181 |
| Mollisia caesia | CBS 220.56T | - | MH857591 | MT026503 |
| Mollisia dextrinospora | CBS 401.78T | - | NR119489 | MH872917 |
| Mollisia rosae | CBS 230.71T | - | MH860088 | MH871865 |
| Phlyctema phoenicis | CPC 29372T | - | NR155690 | NG067319 |
| Phlyctema vincetoxici | CBS 123727T | - | NR145310 | NG067282 |
| Pichia membranifaciens | CBS 107T | NG064813 | NR111195 | NG042444 |
| Pseudofabraea citricarpa | CBS 130297T | - | NR154319 | NG069282 |
| Saccharomyces cerevisiae | CBS 1171T | NG063315 | NR111007 | NG042623 |
| Saccharomycodes ludwigii | CBS 821T | NG063254 | NR165986 | NG042629 |
| Saprochaete chiloensis | CBS 8187T | NG070306 | AY788349 | MK834538 |
| Saprochaete saccharophila | CBS 252.91T | NG070310 | AY788309 | MK834545 |
| Saturnispora dispora | CBS 794T | EF550358 | NR155832 | NG055103 |
| Savitreea pentosicarens | DMKU-GTCP10-8T | NG073529 | NR172171 | NG073813 |
| Scheffersomyces stipitis | NRRL Y-7124T | NG063362 | NR165947 | NG042637 |
| Sporopachydermia lactativora | CBS 6192T | - | NR111310 | KY109772 |
| Starmerella bombicola | NRRL Y-17069T | JQ698924 | NR121483 | NG042648 |
| Starmerella geochares | CBS 6870T | NG065473 | KJ630497 | NG060806 |
| Tortispora caseinolytica | CBS 7781T | NG065577 | NR154482 | NG055343 |
| Torulaspora delbrueckii | CBS 1146T | NG061300 | NR111257 | NG058413 |
| Tremella mesenterica | CBS 6973T | - | NR155937 | NG069419 |
| Trichomonascus petasosporus | CBS 9602T | NG062797 | NR155940 | NG055332 |
| Trichosporiella cerebriformis | CBS 135.68T | - | NR155940 | MH859089 |
| Trichosporiella flavificans | CBS 760.79T | OK275050 | MH873011 | OK298462 |
| Trichosporiella flavificans | DMKU-GTSC2-8 | OK275046 | MN460331 | OK283398 |
| Trichosporiella flavificans | DMKU-GTSC2-2 | OK275045 | MN460330 | OK283396 |
| Trichosporiella flavificans | DMKU-GTCC5-6 | OK275047 | MN460342 | OK283393 |
| Trichosporiella flavificans | DMKU-GTCC5-12 | OK275048 | MN460340 | OK283395 |
| Trichosporiella flavificans | DMKU-GTCC5-19 | OK275049 | MN460339 | OK283397 |
| Trichosporiella flavificans | CBS 15,244 (NCAIM Y.02186) | OK275052 | MG250348 | OK298465 |
| Trichosporiella flavificans | CBS 15245 | OK275051 | MZ331540 | OK298467 |
| Trigonopsis variabilis | CBS 1040T | NG061132 | NR154506 | NG055341 |
| Wickerhamiella domercqiae | CBS 4351T | NG061104 | DQ911462 | NG055328 |
| Wickerhamiella infanticola | CBS 7922T | - | NR155985 | NG058278 |
| Wickerhamiella osmotolerans | DMKU VGT1-14T | MN192121 | MN194615 | MH141490 |
| Wickerhamiella sorbophila | CBS 6739T | - | NR155987 | NG055325 |
| Zygoascus hellenicus | CBS 5839T | NG063434 | NR111258 | AY447007 |
| Yeasts | Nucleotide Substitution (bp)/Gap (bp)/Percentage of Sequence Similarity (%) | ||
|---|---|---|---|
| SSU | ITS | D1/D2 | |
| CBS 15,240 (NCAIM Y.01958) | 2/0/99.9 | 0/0/100 | 0/0/100 |
| CBS 15,241 (NCAIM Y.02184) | 0/0/100 | 0/0/100 | 0/0/100 |
| CBS 15,243 (NCAIM Y.02185) | 0/0/100 | 0/0/100 | 0/0/100 |
| CBS 15242 | 0/0/100 | 0/1/99.9 | 0/0/100 |
| CBS 15014 | 0/0/100 | 0/1/99.9 | 2/0/99.6 |
| CBS 161.94 | 0/0/100 | 0/0/100 | 0/0/100 |
| CBS 142641 | 0/0/100 | 0/1/99.9 | 0/0/100 |
| Yeasts | Nucleotide Substitutions (bp)/Gaps (bp)/Percentage of Sequence Similarity (%) | ||
|---|---|---|---|
| SSU | ITS | D1/D2 | |
| T. flavificans DMKU-GTSC2-8 | 0/0/100 | 0/0/100 | 0/0/100 |
| T. flavificans DMKU-GTSC2-2 | 1/0/99.9 | 1/0/99.8 | 0/0/100 |
| T. flavificans DMKU-GTCC5-6 | 1/0/99.9 | 1/1/99.8 | 0/1/99.8 |
| T. flavificans DMKU-GTCC5-12 | 0/0/100 | 3/6/98.6 | 0/0/100 |
| T. flavificans DMKU-GTCC5-19 | 0/0/100 | 1/2/99.8 | 0/1/99.8 |
| T. flavificans CBS 15,244 (NCAIM Y.02186) | 0/0/100 | 0/0/100 | 0/0/100 |
| T. flavificans CBS 15245 | 0/0/100 | 1/1/99.9 | 0/0/100 |
| Physiological Characteristics | 1 | 2 | 3 |
|---|---|---|---|
| Fermentation | |||
| Glucose | v | + | - |
| Galactose | v | v | - |
| Lactose | - | - | - |
| Maltose | v | - | - |
| Melibiose | - | - | - |
| Sucrose | - | - | - |
| Trehalose | - | v | - |
| Raffinose | - | - | - |
| Carbon assimilation | |||
| D-glucose | + | + | + |
| Galactose | + | + | + |
| Sorbose | + | v | v |
| Cellobiose | + | + | + |
| Lactose | w | + | - |
| Maltose | w | + | + |
| Melibiose | w | - | - |
| Sucrose | w | v | + |
| Trehalose | + | + | + |
| Melezitose | w | v | + |
| Raffinose | w | v | - |
| Inulin | - | - | - |
| Starch | v | v | - |
| D-arabinose | + | v | - |
| L-arabinose | + | + | + |
| D-ribose | + | + | - |
| L-rhamnose | + | - | - |
| D-xylose | + | + | + |
| Galactitol | w | - | - |
| Erythritol | + | + | + |
| D-glucitol | s/w | v | + |
| Inositol | s/w | - | - |
| D-mannitol | s/w | v | + |
| Glycerol | + | + | + |
| Ribitol | + | v | - |
| Ethanol | + | s/w | + |
| Methanol | s/w | s/w | - |
| Citric acid | - | - | - |
| Lactic acid | + | + | - |
| Succinic acid | + | + | + |
| D-gluconic acid | + | v | - |
| D-glucuronic acid | - | - | nd |
| D-galacturonic acid | - | - | nd |
| α-Met-D-glucoside | + | - | + |
| Salicin | w | + | + |
| N-acetyl-D-glucosamine | + | + | + |
| D-Glucono-5-lactone | w | + | nd |
| 2-Keto-D-gluconate | w | v | - |
| 5-Keto-D-gluconate | w | - | - |
| Nitrogen assimilation | |||
| (NH4)2SO4 | + | + | nd |
| KNO3 | w | v | - |
| NaNO2 | w | w | nd |
| Ethylamine-HCl | + | + | nd |
| L-lysine | + | + | nd |
| Cadaverine | + | + | + |
| Others | |||
| Diazonium Blue B | - | - | nd |
| Starch-like compounds | - | - | - |
| Growth at vitamin free medium | - | - | - |
| Urea hydrolysis | - | - | nd |
| Growth at 15 °C | + | + | nd |
| Growth at 25 °C | + | + | + |
| Growth at 30 °C | + | + | + |
| Growth at 35 °C | v | + | + |
| Growth at 37 °C | v | + | + |
| Growth at 40 °C | - | + | - |
| Growth at 42 °C | - | - | - |
| Growth at 45 °C | - | - | - |
| 0.1% Cycloheximide resistance | v | - | + |
| 0.01% Cycloheximide resistance | v | - | + |
| Growth in medium supplemented with 50% glucose | + | v | nd |
| Growth in medium supplemented with 60% glucose | + | + | nd |
| Growth in medium supplemented with 5% glucose +10%NaCl | + | + | + |
| Growth in medium supplemented with 5% glucose +16%NaCl | - | - | nd |
| Acid production | v | v | nd |
Publisher’s Note: MDPI stays neutral with regard to jurisdictional claims in published maps and institutional affiliations. |
© 2022 by the authors. Licensee MDPI, Basel, Switzerland. This article is an open access article distributed under the terms and conditions of the Creative Commons Attribution (CC BY) license (https://creativecommons.org/licenses/by/4.0/).
Share and Cite
Sakpuntoon, V.; Péter, G.; Groenewald, M.; Dlauchy, D.; Limtong, S.; Srisuk, N. Description of Crinitomyces reliqui gen. nov., sp. nov. and Reassignment of Trichosporiella flavificans and Candida ghanaensis to the Genus Crinitomyces. J. Fungi 2022, 8, 224. https://doi.org/10.3390/jof8030224
Sakpuntoon V, Péter G, Groenewald M, Dlauchy D, Limtong S, Srisuk N. Description of Crinitomyces reliqui gen. nov., sp. nov. and Reassignment of Trichosporiella flavificans and Candida ghanaensis to the Genus Crinitomyces. Journal of Fungi. 2022; 8(3):224. https://doi.org/10.3390/jof8030224
Chicago/Turabian StyleSakpuntoon, Varunya, Gábor Péter, Marizeth Groenewald, Dénes Dlauchy, Savitree Limtong, and Nantana Srisuk. 2022. "Description of Crinitomyces reliqui gen. nov., sp. nov. and Reassignment of Trichosporiella flavificans and Candida ghanaensis to the Genus Crinitomyces" Journal of Fungi 8, no. 3: 224. https://doi.org/10.3390/jof8030224
APA StyleSakpuntoon, V., Péter, G., Groenewald, M., Dlauchy, D., Limtong, S., & Srisuk, N. (2022). Description of Crinitomyces reliqui gen. nov., sp. nov. and Reassignment of Trichosporiella flavificans and Candida ghanaensis to the Genus Crinitomyces. Journal of Fungi, 8(3), 224. https://doi.org/10.3390/jof8030224

